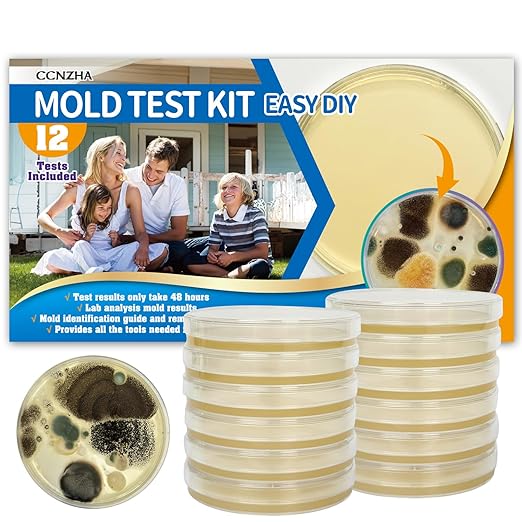
Mold Test Kit for Home -DIY Mold Testing Kit with 12 Individual Tests-Black Mold Detector-Indoor Air Quality Tester-Mold Identification Guide-Free Lab Analysis-Fast and Reliable Mold Detector at Home
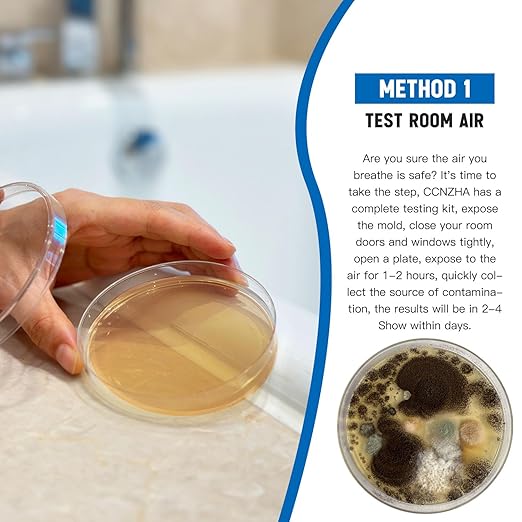

CCNZHA
Mold Test Kit for Home -DIY Mold Testing Kit with 12 Individual Tests-Black Mold Detector-Indoor Air Quality Tester-Mold Identification Guide-Free Lab Analysis-Fast and Reliable Mold Detector at Home
Mold Test Kit for Home -DIY Mold Testing Kit with 12 Individual Tests-Black Mold Detector-Indoor Air Quality Tester-Mold Identification Guide-Free Lab Analysis-Fast and Reliable Mold Detector at Home
Couldn't load pickup availability
About This
- Complete Test Kit :12 test plates,allowing you to conduct thorough and extensive mold assessments throughout your home,swabs,sealed bag, label sheets and test gloves,detailed mold identification guide,our kit contains everything you need.
- Identify Household Molds:Test room air,HVAC system,any household surface, from attic,basement, car,bedroom, car, kitchen, office, other areas.Get a complete picture of how your home is affected by mold in 48 hours!
- Mold Guide And Free Lab Analysis:The detailed mold identification guide helps you identify common household molds and provides methods for mold removal. You can also send us photos of the mold and we will provide you mold analysis for free.
- Cost-Effective Mold Test Kit:Helping you identify toxic molds like black mold without postage, expensive laboratory fees, or long waits, keeping your health free from mold troubles.
- Safe And User-Friendly:This mold detector for home use is crafted for safety and ease, offering straightforward instructions for all three testing methods, facilitating a stress-free DIY mold detection experience.